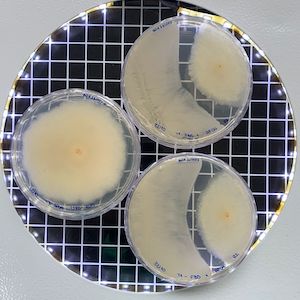
Novo biofungicida multissítio amplia controle de doenças foliares e reduz risco de surgimento de resistência em importantes culturas agrícolas

Novo biofungicida multissítio amplia controle de doenças foliares e reduz risco de surgimento de resistência em importantes culturas agrícolas
Com formulação única no mercado à base de três cepas de Bacillus e mecanismo de ação multissítio, o recém registrado Forblend FS Premium, da Apoena Agro, surge como uma nova ferramenta para o manejo integrado de doenças, apresentando ganhos médios de 11,7 sc/ha em pesquisas à campo em culturas como a soja

As doenças foliares seguem entre os principais fatores de perda nas grandes culturas do Brasil, reduzindo o potencial produtivo e elevando os custos de manejo a cada safra. O avanço de fungos resistentes, favorecido pelo uso repetitivo de defensivos químicos, tem pressionado os sistemas produtivos e exigido novas estratégias dentro do manejo integrado. Nesse contexto, os produtos biológicos vêm se consolidando como ferramentas essenciais por oferecerem mecanismos de ação distintos dos fungicidas convencionais, ampliando o controle das doenças e contribuindo para reduzir a pressão de resistência. Além de atuarem diretamente sobre os patógenos, tornam o manejo mais sustentável, sem deixar resíduos e com menor impacto sobre o ambiente de produção.
O Brasil, país com maior biodiversidade do planeta, é lar de microrganismos únicos, com potencial para o desenvolvimento de bioinsumos capazes de promover resultados expressivos em campo. Por meio da bioprospecção, processo que envolve a coleta, o isolamento e a caracterização desses microrganismos, é possível mapear suas funções biológicas para selecionar aqueles com maior relevância agronômica, princípio que orienta o trabalho da Apoena Agro, empresa de biotecnologia que mantém um banco com mais de 800 cepas, obtidas em expedições conduzidas em biomas como Amazônia e Fernando de Noronha.
Além de fonte de matéria-prima, essa base microbiológica exclusiva permite com que a empresa desenvolva formulações exclusivas, baseadas em combinações de cepas selecionadas e proprietárias, garantindo mecanismos de ação únicos e performance consistente em diferentes condições de campo – como é o caso do Forblend FS Premium, biofungicida multissítio elaborado a partir de um consórcio de bactérias do gênero Bacillus e recentemente aprovado para uso agrícola pelos órgãos reguladores, MAPA, IBAMA e ANVISA.

“Trata-se de uma tecnologia desenvolvida para o controle de doenças foliares que atua como ferramenta complementar dentro do manejo tradicional, aliando produtividade, sustentabilidade e capacidade de controle por meio de múltiplos mecanismos de ação sobre os fungos. Com atuação ampla e efeito protetor, contribui para reduzir o surgimento de resistências em fungos patogênicos e ampliar o controle de doenças e manchas foliares, além de gerar incrementos consistentes de produtividade. Na soja, por exemplo, os estudos em campo demonstraram incrementos médios de 11,7 sacas por hectare. Esse desempenho está diretamente relacionado ao seu caráter multissítio, que permite interferir simultaneamente em diferentes etapas do desenvolvimento e do metabolismo dos fungos, reduzindo a probabilidade de seleção de resistência, um desafio crescente no manejo de doenças, especialmente em culturas como a soja”, afirma Bruno Carillo, CEO da Apoena Agro.
Composto pelos microrganismos Bacillus velezensis DC81, Bacillus velezensis DC88 e Bacillus pumillus DC61, a solução se destaca pela atuação integrada dessas cepas, que atuam diretamente sobre os fungos e estimulam as respostas naturais da planta, dificultando a instalação e o avanço dos patógenos desde as fases iniciais da infecção por meio da produção de metabólitos bioativos, da competição por espaço e nutrientes e da formação de uma barreira protetora na superfície foliar.
Esses mecanismos atuam de forma sinérgica e ao longo de todo o ciclo da cultura, potencializando o efeito de controle. A competição por espaço e nutrientes cria um ambiente menos favorável à instalação dos patógenos, enquanto a liberação contínua de metabólitos bioativos – antibióticos naturais produzidos pelas cepas – mantém pressão constante sobre os fungos, limitando seu desenvolvimento e dificultando sua adaptação ao interferir em sua fisiologia e na integridade da parede celular. Paralelamente, a ativação das defesas naturais da planta amplia a capacidade de resposta do hospedeiro frente a novos episódios de infecção, efeito que é reforçado pela produção de enzimas e pela formação do biofilme protetor, que atuam como camadas adicionais de proteção e reduzem a penetração e o avanço dos patógenos na superfície foliar.
Dessa forma, ao integrar ações diretas e indiretas sobre os fungos com o estímulo às respostas fisiológicas da planta, a tecnologia promove um controle mais estável e duradouro das doenças, o que explica seu caráter multissítio. A combinação das três cepas exclusivas de Bacillus amplia ainda a consistência do desempenho em diferentes condições de campo, graças à elevada capacidade de estabelecimento na superfície foliar e à diversidade de metabólitos bioativos produzidos, que ampliam o espectro de ação, contribuem para a manutenção da microbiota benéfica e dificultam o avanço dos patógenos ao longo do ciclo da cultura.

“Sua formulação em suspensão concentrada garante ampla compatibilidade com a maior parte dos fertilizantes e defensivos agrícolas, oferecendo ao produtor praticidade e segurança operacional. Ao atuar de forma complementar aos fungicidas químicos, o Forblend FS Premium reforça o controle das doenças e se integra facilmente aos programas de manejo já utilizados nas lavouras. Além disso, por ser uma solução sem resíduos, sem fitotoxicidade e carência zero, contribui para um manejo mais sustentável e seguro no campo”, continua Bruno.
Resultados em campo — Os testes de eficácia agronômica do Forblend FS Premium foram conduzidos em 2024, em parceria com a Consultoria Juliagro, em diferentes estados e regiões agrícolas do país, sob distintos sistemas de manejo e condições edafoclimáticas, o que reforça a consistência do desempenho do produto quando avaliado em realidades produtivas diversas. Os ensaios abrangeram as culturas da soja, feijão, cana-de-açúcar, tomate e alface, com experimentos realizados em quatro regiões representativas: Catalão (GO), Uberlândia (MG), Querência (MT) e Cristais Paulistas (SP).

Dentre os principais patógenos avaliados estão Alternaria solani (pintura preta grande), Colletotrichum falcatum (podridão vermelha da cana), Colletotrichum lindemuthianum (antracnose), Botrytis cinerea (mofo cinzento), Sclerotinia sclerotiorum (mofo branco), Corynespora cassiicola (mancha-alvo), Cercospora kikuchii (cercosporiose) e Septoria glycines (septoriose), compondo um espectro amplo de doenças de relevância econômica para diferentes culturas.

Em comparações diretas com produtos referência amplamente utilizados no mercado, o Forblend FS Premium apresentou desempenho superior tanto no controle das doenças quanto nos ganhos adicionais de produtividade, evidenciando que, além de efetivo, o biofungicida multissítio se posiciona como uma alternativa tecnicamente competitiva dentro dos programas de manejo. Na cultura do feijão, por exemplo, visando o controle da doença antracnose (Colletotrichum lindemuthianum), a tecnologia demonstrou, na comparação com o produto referência, redução de 39,93% na incidência e 43,66% na severidade, resultando em um incremento de produtividade de 4,5 sacas por hectare.

Os ensaios também evidenciaram reduções expressivas no avanço dos principais patógenos avaliados em culturas como cana-de-açúcar e hortifruti. Para pinta preta grande (Alternaria solani), o Forblend FS Premium reduziu a severidade em 58% e proporcionou 32,8% de incremento produtivo. No caso da podridão vermelha da cana (Colletotrichum falcatum), o produto conseguiu conter o patógeno em mais de 53% tanto na incidência quanto no grau de dano observado. Para a doença mofo-branco (Sclerotinia sclerotiorum), o biofungicida mostrou seu melhor desempenho, com queda de 64,2% no nível de ataque e 54,4% na ocorrência do patógeno.
Nas doenças da soja, a consistência dos resultados foi confirmada a partir da condução de doze trabalhos experimentais, com quatro estudos dedicados a cada uma das principais doenças avaliadas: mancha-alvo (Corynespora cassiicola), cercosporiose (Cercospora kikuchii) e septoriose (Septoria glycines). A análise consolidada desses ensaios indicou incremento médio de produtividade de 11,7 sacas por hectare, além de reduções expressivas na severidade das doenças, com quedas médias de 55% na cercosporiose, 58% na mancha-alvo e 64% na septoriose, reforçando a eficiência da tecnologia no manejo das principais doenças foliares da cultura e sua contribuição para sistemas produtivos mais estáveis.
Modelo B2B, inovação em biológicos e portfólio em expansão — O biofungicida multissítio da Apoena Agro já possui registro no MAPA, ANVISA e IBAMA e, desde dezembro de 2025, integra oficialmente o seu portfólio. Todas as tecnologias desenvolvidas são ofertadas no modelo B2B, atendendo players do setor de insumos agrícolas que desejam ampliar sua atuação no segmento de biológicos. A empresa conduz todo o processo — da bioprospecção ao desenvolvimento, validação em campo e registro —, entregando soluções prontas para formulação e comercialização, reduzindo o tempo de entrada no mercado e ampliando o acesso a tecnologias baseadas na biodiversidade brasileira. Além do Forblend FS Premium, outras soluções devem ser incorporadas ao seu portfólio em 2026, em linha com sua estratégia de fortalecer a oferta de tecnologias biológicas para o mercado.
O trabalho de pesquisa da empresa também avança de forma contínua: além de duas expedições já realizadas na Amazônia e duas no arquipélago de Fernando de Noronha, novos biomas devem ser estudados em 2026, com o objetivo de ampliar o banco de microrganismos nativos e acelerar o desenvolvimento de bioinsumos de nova geração. A Apoena Agro também avalia a extensão de registro do Forblend FS Premium para novas doenças, como ferrugem da soja, oídio e estria da cana, reforçando seu compromisso com inovação, sustentabilidade e oferta de ferramentas complementares ao manejo convencional.
“Nosso compromisso é ampliar o acesso a soluções biológicas que unam performance agronômica, segurança e sustentabilidade, reduzindo o impacto ambiental do manejo sem comprometer a produtividade. O trabalho de bioprospecção que conduzimos em biomas brasileiros nos permite desenvolver formulações exclusivas, baseadas em cepas selecionadas do nosso próprio banco microbiano. É essa abordagem que transforma a biodiversidade nacional em tecnologias aplicáveis e fortalece o manejo integrado. O Forblend FS Premium integra esse movimento e reforça a evolução contínua do nosso portfólio de bioinsumos”, finaliza o CEO da Apoena Agro.
Saiba mais em www.apoenaagro.com.br






